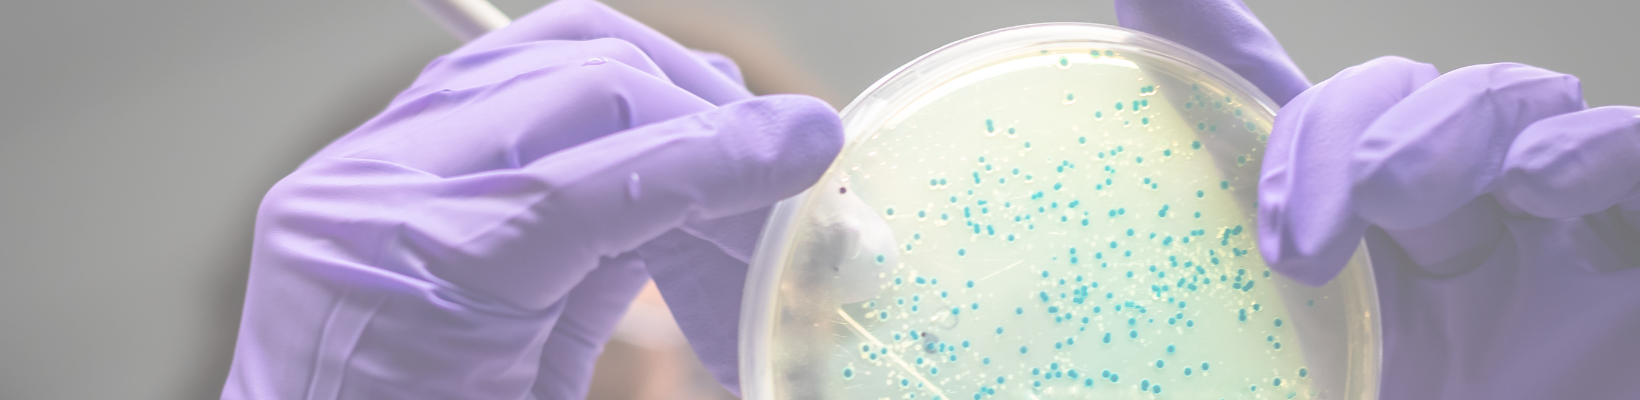

Introduction
Deep within our bodies exists a fascinating and intricate world—the gut microbiome. This remarkable ecosystem, composed of trillions of microorganisms including bacteria, archaea, bacteriophages, and eukaryotes, holds immense influence over our immune and metabolic health. However, our understanding of this hidden universe has remained limited, primarily focused on industrialised populations. Thankfully, a groundbreaking study conducted by scientists from Stanford University, published in the esteemed Cell journal’s June issue, has shed unprecedented light on the profound impact of industrialisation on the human gut microbiome. By delving into the microscopic realm, the researchers embarked on an awe-inspiring journey alongside the Hadza hunter-gatherers of Tanzania, as well as comparative populations in Nepal and California.
In this thought-provoking blog post, we embark on a journey deep into the world of the gut microbiome, exploring how industrialisation has dramatically altered its composition and functionality. Join us as we delve into this captivating exploration, unraveling the mysteries of the world within us. We will explore the vanishing species, the profound impacts of industrialisation, and the unique aspects of the Hadza gut microbiome. Whether you are a science enthusiast, health-conscious individual, or simply curious about the wonders that lie within, this journey promises to enlighten you about the gut microbiome—a hidden ecosystem that holds the key to our well-being and may forever change the way we perceive ourselves.

The gut microbiome: An intricate ecosystem within
Imagine, if you will, a bustling metropolis inside your gastrointestinal tract—an intricately connected community of microorganisms that call our gut their home. These tiny inhabitants, collectively known as the gut microbiome, play a remarkable role in maintaining our immune system, metabolising nutrients, and even influencing our mood. Rather than passive passengers, these microorganisms are active participants, communicating and collaborating with each other to form a delicate balance that affects our overall well-being. Like an orchestra, the gut microbiome works harmoniously, producing vital metabolites, vitamins, and enzymes that support our body’s functions.
What makes the gut microbiome even more fascinating is its incredible diversity. Just as a thriving ecosystem relies on a wide array of species, the gut microbiome thrives on its rich tapestry of microorganisms. Each person carries their unique blend of microbial communities, akin to a fingerprint, shaped by factors such as genetics, diet, lifestyle, and environment.
However, the rapid rise of industrialization has introduced significant changes to our modern lifestyles and environments, inadvertently disrupting the delicate balance of our gut microbiome. Factors such as processed foods, widespread antibiotic use, and reduced exposure to diverse environments have thrown this once harmonious system off balance.

Industrialisation has a heavy toll on gut microbes
Industrialisation, with its rapid advancements and changes in our way of life, has taken a toll on the delicate balance of our gut microbiome—the complex ecosystem of microorganisms residing within our digestive system. This toll has had a significant impact on the composition and functionality of these essential microbes, with far-reaching consequences for our health.
One of the primary ways industrialisation affects our gut microbes is through shifts in our diet. The rise of processed foods, high in refined sugars and unhealthy fats, has become pervasive in our modern food systems. These dietary changes not only deprive our gut microbes of the nutrients they need to thrive but also promote the growth of certain harmful bacteria. As a result, the diversity and richness of our gut microbiome decline, paving the way for potential health problems.
Furthermore, the widespread use of antibiotics, a hallmark of modern medicine, has had unintended consequences for our gut microbes. While antibiotics are crucial for treating bacterial infections, they can also disrupt the delicate balance of our gut microbiome. Antibiotics are indiscriminate, killing both harmful and beneficial bacteria. This disturbance can lead to long-lasting changes in the composition of our gut microbes, compromising their ability to carry out essential functions and leaving us more susceptible to various health conditions.
The key message here is that industrialisation has profoundly altered our gut microbiome, jeopardising the intricate harmony that existed between these microorganisms and our bodies for thousands of years. These changes have contributed to a decrease in microbial diversity, the loss of beneficial species, and an increase in potentially harmful microbes.

Ultra-deep sequencing unveils the invisible
Imagine a world where we can peer through a powerful microscope, revealing the hidden microcosm that exists within us. Thanks to a groundbreaking scientific technique known as ultra-deep sequencing, researchers have unlocked the secrets of this previously unseen realm—the gut microbiome. Ultra-deep sequencing is akin to using a super powered magnifying glass to examine the genetic makeup of the myriad microorganisms residing within our digestive system. By sequencing their DNA, scientists can identify and understand different types of microbes in great detail.
In this extraordinary study, scientists from Stanford University utilised ultra-deep sequencing to investigate the gut microbiomes of the Hadza hunter-gatherers of Tanzania. These individuals, living a traditional lifestyle closely connected to the land and following a diet distinct from the typical Westernised diet, provide a unique window into the human gut microbiome. By comparing the gut microbiomes of the Hadza people with those of individuals from Nepal and California, the scientists aimed to unravel the impact of industrialisation on our gut microbes.
The extensive sequencing unravelled the genetic makeup of microbes comprising of over 90,000 genomes, encompassing a wide range of microorganisms including bacteria, bacteriophages, archaea, and eukaryotes. Astonishingly, 44% of these microbial genomes had not been previously documented in comprehensive databases like the Unified Human Gastrointestinal Genome database. The Hadza samples, in particular, provided remarkable insights as the researchers discovered over 1,000 previously unknown bacterial or archaeal species through the genome sequences. This discovery represents a significant contribution to the field of microbiology, expanding our understanding of the diverse and complex microbial communities that inhabit the human gut.
So, envision a team of scientists armed with powerful tools, exploring the hidden world of microbes within us, and illuminating the remarkable connection between our lifestyle choices and this invisible ecosystem. This groundbreaking study bridges the gap between science and our everyday lives, showing us that even the tiniest creatures can have a profound impact on our health.

The alarming disappearance gut-resident species
In the groundbreaking study conducted by scientists from Stanford University, a startling revelation emerged. They discovered that 124 gut-resident species, which have co-evolved with us for countless generations, are now teetering on the edge of vanishing altogether in industrialised populations. This loss serves as a stark reminder of the extensive perturbation induced by the modern way of life.
Imagine an intricate tapestry woven by these microorganisms, each contributing their unique capabilities to our well-being. Now, picture threads being pulled, gaps appearing, and the tapestry unraveling before our eyes. This is precisely what industrialisation has done to the delicate balance of our gut microbiome, resulting in the loss of these vital species.
Why is this disappearance alarming? These gut-resident species have played crucial roles in functions such as digestion, nutrient absorption, immune system regulation, and even mental health. Without them, our gut microbiome becomes imbalanced and less diverse, potentially leading to various health issues. The loss of these 124 gut-resident species serves as a sobering reminder of the impact that our modern lifestyle has on the invisible world within us. It highlights the urgent need to understand and address the consequences of industrialisation on our gut microbiome, as its delicate equilibrium is disrupted.
By shedding light on this concerning trend, researchers hope to raise awareness about the importance of preserving the diversity and integrity of our gut microbiome. Exploring ways to restore and nurture these vanishing species could open doors to innovative approaches for maintaining and improving our health.
Unique aspects of the Hadza gut microbiome
The gut microbiome of the Hadza people, a group of hunter-gatherers in Tanzania, holds intriguing and unique characteristics when compared to populations living in more industrialised settings. Two of these fascinating aspects are “in situ replication rates” and “strain sharing.”
“In situ replication rates” refer to the speed at which the microorganisms in the gut microbiome reproduce or replicate. In the case of the Hadza people, their gut microbes have been found to replicate at different rates compared to those in industrialised populations. This suggests that the microorganisms in the Hadza gut are reproducing at a pace that suits the Hadza lifestyle and diet, finely tuned over generations.
On the other hand, “strain sharing” refers to the presence of similar or shared microbial strains among individuals within a population. Interestingly, the Hadza gut microbiome exhibits distinct patterns of strain sharing, which means that certain microbial strains are commonly found among different individuals in their community. This sharing of strains may be attributed to factors such as their close proximity, shared food sources, or other interactions within their social structure.
These unique characteristics of the Hadza gut microbiome shed light on how the Hadza people’s traditional way of life and diet shape their gut microbial composition. The in situ replication rates indicate that their gut microbes have adapted to their specific lifestyle, reflecting the long-standing coexistence between the Hadza people and their gut microbiome. The strain sharing aspect suggests a close microbial connection within the Hadza community. This sharing of microbial strains may be due to factors such as their communal lifestyle, frequent interactions, and sharing of resources.
By studying and understanding these distinct features of the Hadza gut microbiome, researchers gain valuable insights into the impact of different lifestyles and environments on the microbial communities living within us. These findings not only deepen our understanding of the Hadza people’s unique relationship with their gut microbes but also contribute to our broader knowledge of the diversity and adaptability of the human gut microbiome.

Gut microbes help in adapting to inflammatory processes
When our bodies encounter inflammation—a response to various triggers such as injury or infection—it turns out that our gut microbiome plays a role in adapting to these inflammatory processes. Researchers have discovered that the microbial communities residing in our gut exhibit a notable enrichment of genes associated with oxidative stress.
To understand this phenomenon, let’s break it down: Oxidative stress occurs when there is an imbalance between the production of harmful molecules called reactive oxygen species (ROS) and the body’s ability to neutralise them with antioxidants. During inflammation, the immune system produces ROS as part of its defence mechanism against pathogens. However, excessive ROS can also damage healthy cells and tissues. In response to this oxidative stress, our gut microbiome demonstrates a fascinating adaptability. It appears that over time, the microbial populations within our gut have evolved to cope with these inflammatory processes. This adaptation is reflected in the enrichment of genes related to oxidative stress that are present in industrialised gut microbiomes.
Why would the gut microbiome develop such an adaptation? One possibility is that the microbiome has adjusted to the chronic low-grade inflammation associated with modern lifestyles, such as poor dietary choices and sedentary behaviour. These factors can trigger a continuous state of mild inflammation, and the gut microbiome may have undergone changes to better survive and thrive in this environment. However, it’s important to note that while this adaptation may have its benefits in the context of inflammation, it can also have implications for our overall health. Excessive oxidative stress, even if partially managed by the gut microbiome, can still contribute to the development of chronic diseases, including cardiovascular conditions and certain cancers.
Understanding the enrichment of genes associated with oxidative stress in the gut microbiome expands our knowledge of the intricate relationship between our bodies and these microbial communities. It serves as a reminder that our lifestyle choices and the environments we inhabit have a significant impact on the composition and functionality of our gut microbiome, which in turn can influence our health outcomes. By delving deeper into these mechanisms of adaptation, researchers strive to uncover strategies to maintain a balanced gut microbiome and mitigate the potential negative effects of chronic inflammation. By fostering a healthy and diverse gut microbiome through lifestyle interventions such as a nutritious diet, regular exercise, and minimising stress, we can support the microbial communities that contribute to our overall well-being.
Conclusion
In conclusion, the gut microbiome is a powerful and intricate ecosystem within our bodies that plays a crucial role in our overall health. The impact of industrialization on this microbial community cannot be underestimated. Shifts in our diet, characterized by the prevalence of processed foods, and the widespread use of antibiotics have disrupted the delicate balance of our gut microbiome, leading to a decrease in microbial diversity, the loss of beneficial species, and an increase in potentially harmful microbes.
So, what can we do? Understanding the profound influence of industrialisation on our gut microbiome calls for action. We must prioritise the health of our gut microbiome by embracing a diet rich in whole, unprocessed foods and being mindful of antibiotic use. Additionally, advocating for policies that prioritise gut health and supporting scientific research on the gut microbiome are crucial steps towards creating a future where our gut microbiomes thrive, promoting improved overall well-being.
By recognising the intricate connection between our lifestyle choices, the environment, and the gut microbiome, we can make informed decisions that nurture and protect this invisible ecosystem within us. Let us embark on a journey of conscious choices, spreading awareness about the importance of gut health and working together to ensure a healthier future for ourselves and generations to come.
Additional Reading
- Carter MM et al. 2023. Ultra-deep sequencing of Hadza hunter-gatherers recovers vanishing gut microbes. Cell https://doi.org/10.1016/j.cell.2023.05.046
- Gopalan S et al. 2022. Hunter-gatherer genomes reveal diverse demographic trajectories during the rise of farming in Eastern Africa. Current Biology 32: 1852-1860. https://doi.org/10.1016/j.cub.2022.02.050
- Tomofuji Y. et al. 2022. Prokaryotic and viral genomes recovered from 787 Japanese gut metagenomes revealed microbial features linked to diets, populations, and diseases. Cell Genomics 2, 100219. https://doi.org/10.1016/j.xgen.2022.100219
